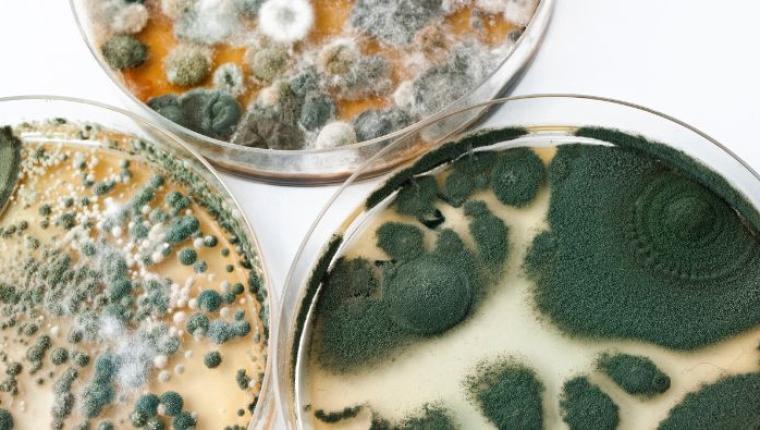
The Fascinating World of Mycology: Discovering the Importance of Fungi

Nature: Understanding Its Importance and Our Responsibility to Protect It
Learn about the importance of nature, biodiversity, climate change, and conservation. Discover how protecting nature ensures a sustainable future.
Top 10 Natural Remedies for Everyday Wellness
Explore 10 powerful natural remedies to enhance your everyday wellness. From herbal teas to essential oils, discover simple, effective ways to stay healthy naturally.
How to Build a Sustainable Lifestyle Using Natural Resources
sustainable lifestyle, natural resources, eco friendly living, renewable energy, low waste lifestyle, green habits, sustainable home, environment friendly living
The Healing Power of Nature: Why Forest Bathing Is Trending in 2025
Discover why forest bathing is the top wellness trend of 2025. Learn how this nature-based therapy improves mental health, reduces stress, and boosts immunity.
The Future of Urban Gardening: How To Start Your Own Green Space
Discover the future of urban gardening and learn how to create your own green space in the city. Find tips on plant selection, sustainable practices, and innovative gardening techniques for a healthier, eco-friendly lifestyle.
Top 10 Travel Destinations You Must Visit This Year
Are you dreaming of your next great adventure? Whether you’re seeking international hotspots or searching for places to visit or tourist attractions near me, this list of must-visit destinations will ignite your wanderlust. From hidden gems to world-renowned holiday destinations, here are the top 10 travel destinations you can’t miss this year.
Forest Bathing: The Japanese Art of Shinrin-Yoku and Its Benefits
In our fast-paced, technology-driven world, finding ways to reconnect with nature is becoming increasingly important for maintaining our mental and physical health. One practice that has gained global recognition for its numerous benefits is Shinrin-Yoku, or forest bathing.
How to Get Kids Excited About Nature
In an era where screens dominate children’s lives, instilling a love for nature can seem challenging. However, nurturing an appreciation for the outdoors is essential for their physical health, mental well-being, and understanding of the environment.
The Fascinating World of Mycology: Discovering the Importance of Fungi
Fungi are often overlooked in the natural world, but they play crucial roles in ecosystems, medicine, and even our daily lives. The study of fungi, known as mycology, reveals their remarkable diversity and the myriad ways they influence our planet.
A Guide to Birdwatching: Tips for Beginners and Where to Spot Rare Species
Birdwatching, or birding, is a rewarding and fascinating hobby that connects you with nature and allows you to observe some of the world's most beautiful and elusive creatures. Whether you're a complete beginner or looking to spot rare species, this guide will provide essential tips and prime locations for birdwatching.
The Benefits of Urban Green Spaces
Urban green spaces, such as parks, gardens, and green roofs, are vital components of city landscapes. They provide numerous benefits that enhance the quality of life for urban residents and contribute to the overall health and sustainability of urban environments.
The Role of Wetlands in the Ecosystem
Wetlands are some of the most valuable ecosystems on Earth, acting as natural buffers, habitats, and resources that support biodiversity, clean water, and climate resilience. Covering just a fraction of the planet’s surface, wetlands offer benefits far beyond their size, providing essential services that sustain countless species—including humans.